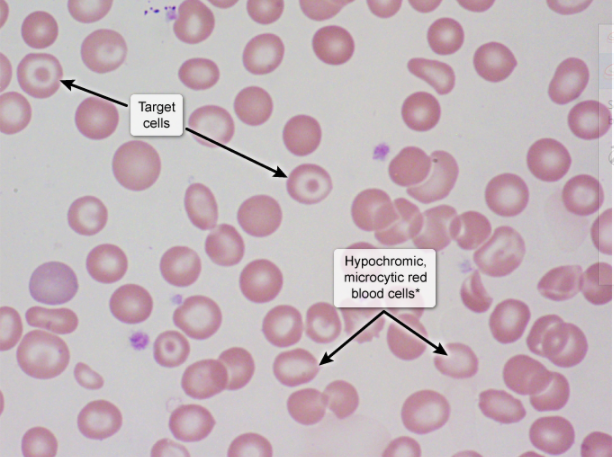

Compensatory mechanisms for hypovolemia include activation of the renin-angiotensin-aldosterone system and increased antidiuretic hormone release. This results in —– renal sodium, chloride, water, and urea reabsorption with increased potassium excretion.
increased
Acute —- infection can cause a serum sickness-like syndrome with joint pain, lymphadenopathy, and a pruritic urticarial rash. Other features may include right upper quadrant pain, hepatomegaly, and elevated hepatic transaminase levels.
hepatitis B
Patients started on warfarin develop a transient hypercoagulable state due to the short half-life of —– This hypercoagulability is further exaggerated by preexisting —- deficiency and can result in thrombotic occlusion of the microvasculature with skin necrosis.
protein C
Sputum in Ashtma, microscopy classically demonstrates elevated levels of eosinophils (granule-containing cells) with Charcot-Leyden crystals (bipyramidal-shaped accumulations of eosinophil membrane protein).
Atopic asthma occurs due to an excessive TH2-mediated reaction to environmental aero-antigens (eg, pollen, pet dander). In response to allergic stimuli, these cells secrete —, a critical cytokine for eosinophilic activation, recruitment, and prolonged survival in the bronchial mucosa. TH2 cells also synthesize IL-4, which stimulates IgE formation by plasma cells.
IL-5
Direct factor Xa inhibitors (eg, apixaban, rivaroxaban) increase the —– and activated —— times but do not affect the thrombin time.
Unfractionated heparin and direct thrombin inhibitors (eg, dabigatran) prolong the thrombin time.
prothrombin and activated partial thromboplastin
low —— can help diagnose pancreatic insufficiency and supports a diagnosis of chronic pancreatitis. Other useful tests include Sudan staining (which identifies fecal fat) and hemoglobin A1c (which diagnoses diabetes mellitus).
fecal elastase
In patients with prolactinoma, high levels of circulating prolactin suppress GnRH secretion from the hypothalamus, leading to reduced secretion of LH and subsequent hypogonadism, anovulation, and amenorrhea. The resulting estrogen deficiency can cause osteoporosis with an increased risk for fragility fractures, and lead to —–
vaginal dryness and atrophy
Von Willebrand disease is the most common inherited bleeding disorder and is usually transmitted in an autosomal dominant fashion. Symptomatic patients typically present with easy bruising and mucosal bleeding. Laboratory evaluation will show —– platelets, —– PT, and either —– PTT due to low levels of factor VIII
normal platelets
normal PT
normal or prolonged PTT
von Willebrand factor (vWF) functions as a promoter of platelet adhesion at sites of vascular injury by binding platelet glycoproteins to subendothelial —- on injured blood vessel walls. It also acts as a protective carrier protein for circulating factor VIII.
collagen
Patients with cystic fibrosis are at risk for fat-soluble vitamin (ie, A, D, E, K) deficiency due to fat malabsorption from pancreatic insufficiency. Vitamin K is an important cofactor in the activation of coagulation factors II, VII, IX, and X. Vitamin K deficiency leads to easy bruising, mucosal bleeding, and —- PT.
prolonged
A low-frequency, late diastolic sound on cardiac auscultation that immediately precedes the first heart sound (S1) is most often a —- heart sound. An abnormal S- can be heard in patients with reduced ventricular compliance (eg, hypertensive heart disease, aortic stenosis, hypertrophic cardiomyopathy) due to a sudden rise in end-diastolic pressure with atrial contraction
fourth
Sudden cessation of passive ventricular filling causes a diastolic — heart sound that is heard shortly after S2. It is often heard in patients with systolic heart failure (eg, dilated cardiomyopathy), ventricular volume overload (eg, mitral regurgitation), and in high-output cardiac states (eg, pregnancy, thyrotoxicosis).
third heart sound (S3)
Salicylate intoxication (like aspirin) should be suspected in patients with the triad of fever, tinnitus, and tachypnea. Salicylates both stimulate central respiratory drive to cause primary respiratory —– and disrupt cellular metabolism to cause primary anion gap metabolic —–. Therefore, toxicity classically presents with a mixed acid-base disturbance and a blood pH sometimes within the normal range
respiratory alkalosis
metabolic acidosis
Gilbert syndrome is characterized by indirect —– due to decreased bilirubin conjugation. Patients have recurrent, self-resolving episodes of scleral icterus and jaundice triggered by stress.
a genetic mutation results in reduced enzymatic activity of UDP glucuronosyltransferase and therefore decreased bilirubin conjugation
bilirubin excretion into the bile duct is normal in Gilbert syndrome, hepatocyte bilirubin storage is also normal, as is liver histology
hyperbilirubinemia
The presence of jugular venous distension and lower extremity edema shortly after pulmonary embolism (PE) are highly suggestive of — heart failure (ie, cor pulmonale) as the cause of this patient’s ascites.
— heart failure promotes the formation of ascites due to increased central venous pressure, which is transmitted to the hepatic sinusoids, leading to increased capillary hydrostatic pressure. Capillary permeability is unaffected. Although chronic passive congestion may eventually result in hepatic synthetic dysfunction (hypoalbuminemia) with low oncotic pressures, the oncotic pressure will remain normal for several weeks at least.
right-sided
Radiation-induced lung injury typically occurs following thoracic irradiation (eg, breast cancer), which damages pneumocytes and vascular endothelial cells and initiates an inflammatory response (eg, IL-1, TNFα, TGF-β). This immune response can have both acute (eg, exudative alveolitis, hyaline membrane formation) and delayed (eg, dense —–) effects that typically manifest with cough and dyspnea.
fibrosis
Survivors of acute respiratory distress syndrome commonly have reduced lung function that persists for months or years and is sometimes permanent. The majority of patients have —– diffusion capacity that eventually normalizes after several years, whereas a small percentage develop extensive fibrosis with a marked and permanent reduction in diffusion capacity.
There is increased alveolar-arterial oxygen gradient that manifests clinically with mild dyspnea.
reduced
patient has a microcytic anemia and increased hemoglobin A2 (α2δ2) concentration. His peripheral blood smear shows hypochromia and poikilocytes, including spherocytes and target cells (arrows). This constellation of findings in an asymptomatic adult of Mediterranean heritage suggests —–
—- is caused by mutations that result in defective transcription, processing, and translation of beta-globin —–
beta-thalassemia minor
mRNA.


